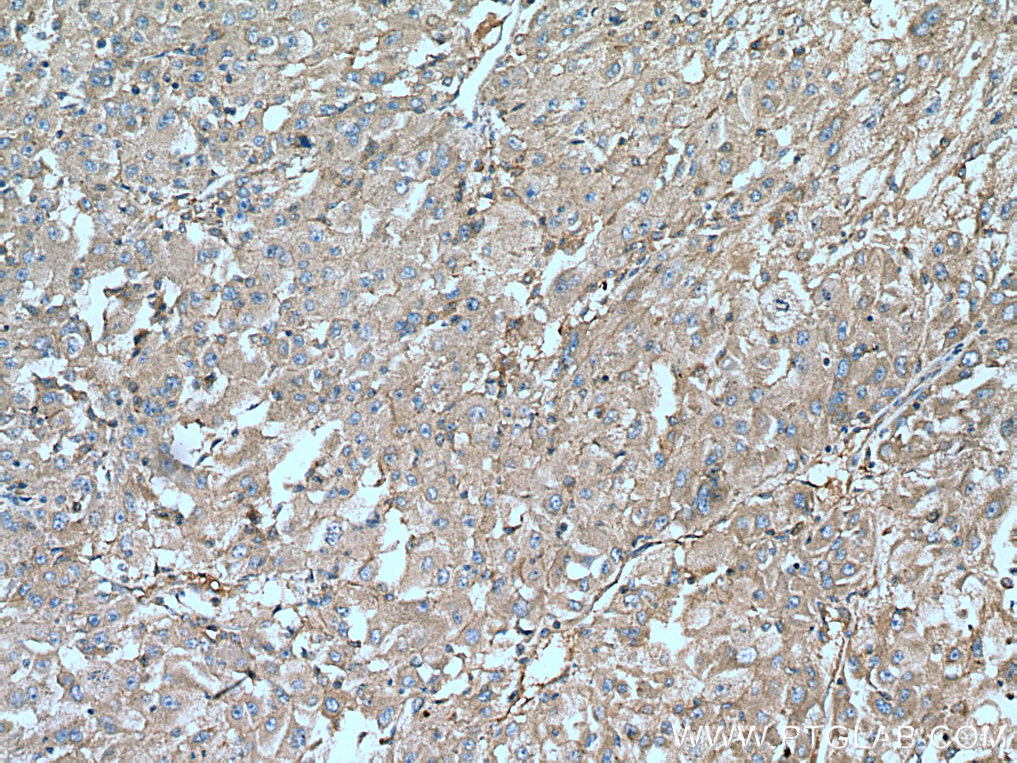

验证数据展示
经过测试的应用
| Positive IHC detected in | mouse liver tissue, human liver cancer tissue Note: suggested antigen retrieval with TE buffer pH 9.0; (*) Alternatively, antigen retrieval may be performed with citrate buffer pH 6.0 |
推荐稀释比
| 应用 | 推荐稀释比 |
|---|---|
| Immunohistochemistry (IHC) | IHC : 1:300-1:1200 |
| It is recommended that this reagent should be titrated in each testing system to obtain optimal results. | |
| Sample-dependent, Check data in validation data gallery. | |
产品信息
20214-1-AP targets IGF1A-Specific in WB, IHC, IF, ELISA applications and shows reactivity with human, mouse samples.
| 经测试应用 | IHC, ELISA Application Description |
| 文献引用应用 | WB, IHC, IF |
| 经测试反应性 | human, mouse |
| 文献引用反应性 | human, mouse, rat, pig |
| 免疫原 |
Peptide 种属同源性预测 |
| 宿主/亚型 | Rabbit / IgG |
| 抗体类别 | Polyclonal |
| 产品类型 | Antibody |
| 全称 | insulin-like growth factor 1 (somatomedin C) |
| 别名 | IGF-1, IGF1, Insulin like growth factor I, IGF-I, IGFI |
| 计算分子量 | 17 kDa |
| 基因名称 | IGF1 |
| Gene ID (NCBI) | 3479 |
| RRID | AB_10666736 |
| 偶联类型 | Unconjugated |
| 形式 | Liquid |
| 纯化方式 | Antigen affinity purification |
| UNIPROT ID | P05019 |
| 储存缓冲液 | PBS with 0.02% sodium azide and 50% glycerol, pH 7.3. |
| 储存条件 | Store at -20°C. Stable for one year after shipment. Aliquoting is unnecessary for -20oC storage. |
背景介绍
IGF1, also named as IBP1, MGF, IGF-IA and Somatomedin-C, belongs to the INS family. IGF1 is structurally and functionally related to INS but have a much higher growth-promoting activity. Altered expression or mutation of IGF-1 is associated with several human disorders, including type I diabetes and various forms of cancer. Defects in IGF1 are the cause of INS-like growth factor I deficiency (IGF1 deficiency) which is an autosomal recessive disorder characterized by growth retardation, sensorineural deafness and mental retardation. The antibody is specific to isoform IGF-1A.
实验方案
| Product Specific Protocols | |
|---|---|
| IHC protocol for IGF1A-Specific antibody 20214-1-AP | Download protocol |
| Standard Protocols | |
|---|---|
| Click here to view our Standard Protocols |
发表文章
| Species | Application | Title |
|---|---|---|
Gastroenterology Regulator of Calcineurin 1 Gene Isoform 4, Downregulated in Hepatocellular Carcinoma, Prevents Proliferation, Migration, and Invasive Activity of Cancer Cells and Growth of Orthotopic Tumors by Inhibiting Nuclear Translocation of NFAT1. | ||
J Hepatol Deficiency of insulin-like growth factor 1 attenuates aging-induced changes in hepatic function: Role of autophagy. | ||
Proc Natl Acad Sci U S A Disruption of the AMPK-TBC1D1 nexus increases lipogenic gene expression and causes obesity in mice via promoting IGF1 secretion. | ||
Int J Cancer Estrogen and insulin-like growth factor synergistically promote the development of lung adenocarcinoma in mice. | ||
Mol Neurobiol Intramuscular Delivery of scAAV9-hIGF1 Prolongs Survival in the hSOD1(G93A) ALS Mouse Model via Upregulation of D-Amino Acid Oxidase. | ||
Cancer Lett IFN-γ-mediated IRF1/miR-29b feedback loop suppresses colorectal cancer cell growth and metastasis by repressing IGF1. |